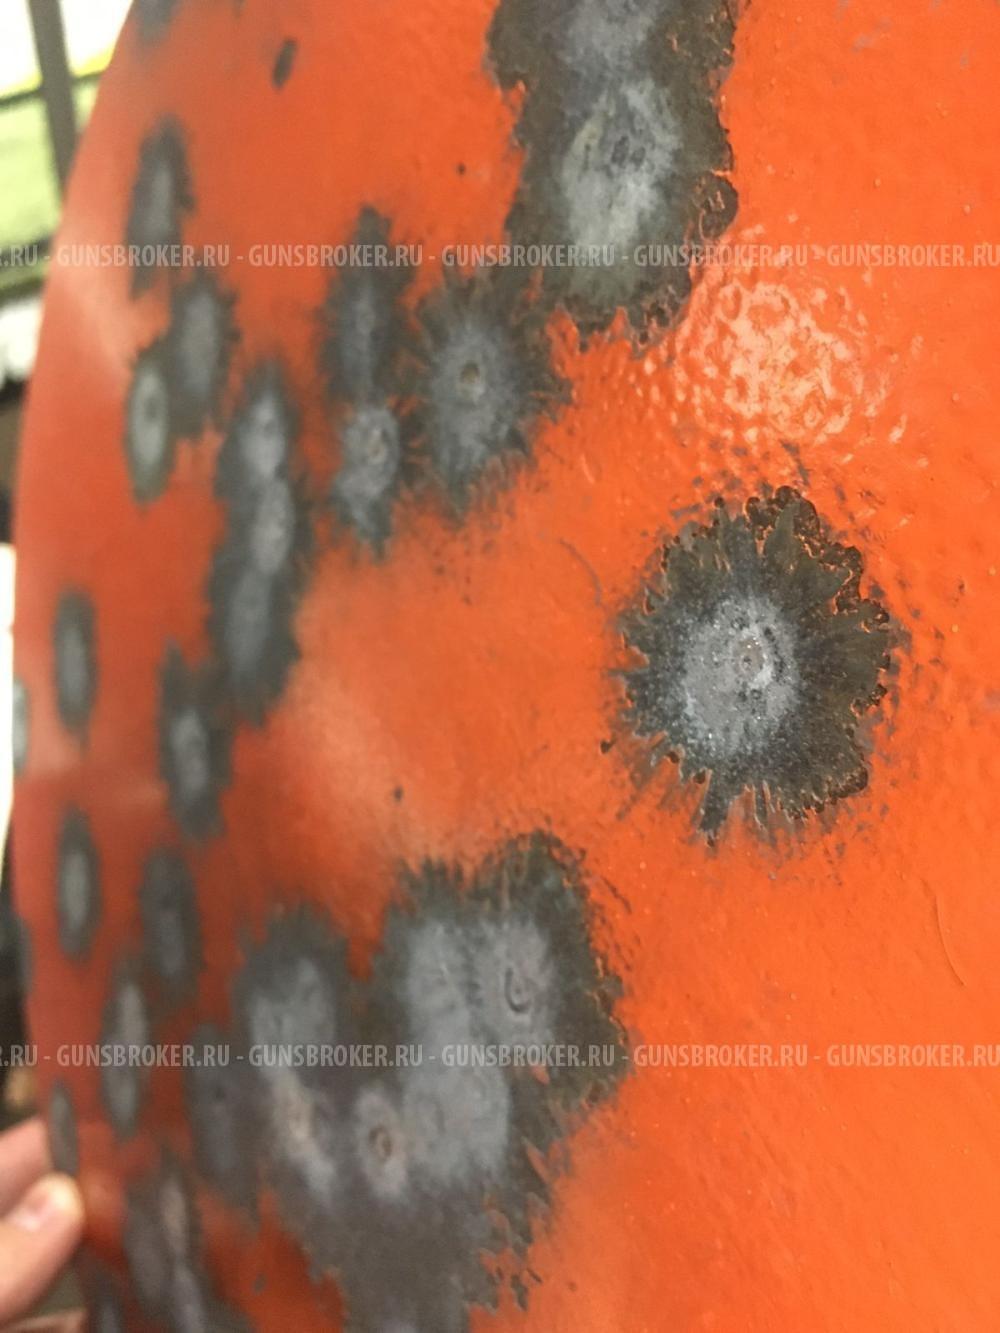
Надёжные гонги для стрельбы — броневая сталь, мощный звон попадания

Надёжные гонги для стрельбы — броневая сталь, мощный звон попадания
Показать телефон
+7 (916) 519-XX-XX
Автор подтвердил, что изделие продаётся в полном соответствии с федеральным законом 'Об Оружии'. Если у вас есть сомнения, или автором предоставлена недостоверная информация - воспользуйтесь кнопкой 'Пожаловаться'.
Охотничье оружие и ОООП продаётся только при наличии лицензии, с обязательной перерегистрацией в органах Росгвардии.
К сожалению, никто не застрахован от встречи с мошенником. Пожалуйста, ознакомьтесь с данной статьей и будьте бдительны.
Если Вы столкнулись с мошенничеством на нашем сайте, напишите нам и обратитесь в правоохранительные органы. Мы предоставим необходимые данные по официальному запросу.
Продам комплект стоек (Super Hide Pole).
4 500 руб. МоскваПродам комплект стоек (телескопических) для маскировочной сетки(Super Hide Pole). Комплект состоит из 4 стоек. Длина рабочая-1700 мм. Длина штыря-155 мм. Длина чехла-1200 мм. Ширина чехла-220 мм. В...
Бронежилет 6б45 2 размер с плитами
33 000 руб. Москва, МоскваБронежилет 6б45 с плитами гранит 2 размер. Состояние практическиновый , быстросброс на месте. Могу отправить
Активные наушники peltor comtac VII 7
80 000 руб. москваНаушники peltor comtac 7 генерации - защита слуха. - радофикация. - возможность объщения без рации до 60ти метров. - гелевые амбюшуры(оригинал) переставил с прошлых. - динамический микрофон. - безп...
Щенка Русского Охотничьего Спаниеля (РОС) от рабочих родителей. РКС, документы.
65 000 руб. МоскваЩенки русского охотничьего спаниеля, от рабочих родителей, плановая вязка РКФ, документы. Инстинкты отличные, лучшие поисковики и подавальщики по перу, верный друг и помощник на охоте. Отправлю в другой ...
Kestrel 2700
19 000 руб. МоскваПродам младшего Kestrel-а. Не пользовался. Комплект коробка, устройство, пластиковый чехол, бумажки. Всё что было в поставке. За время владения сменил батарейку CR2032. Деньги от продажи пойдут на зак...
Новая мембранная куртка армии Франции
10 000 руб. МоскваНовая мембранная куртка армии Франции (ФИЛ), размер 112L (54-56; XL-XXL). Мембрана Gore-T хзex. Длина по спине - 77 см, длина рукава - 58 см, обхват груди - 108-116 см. Крой очень свободный, куртка рассч...
БРС-2 полицейские наручники
3 000 руб. МоскваБРС-2 полицейские наручни (КОНВОЙНЫЕ, обладающие в отличие от оперативных повышенной надежностью, изготавливаются по другой технологии, разная толщина металла и степень его закалки)! Коллекционный экз...
KESTREL 2700 BALLISTICS
40 000 руб. МоскваKESTREL 2700 ballistiks Новый !!! Блютуз +к тел смартфону через приложение. Отправлю ТК сдек пр Яндекс. Made in Usa 🇺🇲 Москва .СВАО Дтк зт БАНКА АЙРМАСТЕР циклон Айрмастер 42000₽...
Подсумок-патронташ на 12 патронов калибра .30-06
500 руб. МоскваПодсумок-патронташ на 12 патронов калибра .30-06 Подсумок-патронташ на 12 нарезных патронов калибра .30-06 дюймов (7,62 мм), армированный нейлоновый
Цифровой измеритель уровня звука HoldPeak HP-882A,
4 500 руб. Москва, Москва или РязаньПродаю новый цифровой измеритель уровня звука HP-882A Тестер измерителя уровня шума Диапазон от 30 до 130 дБ, цифровой измеритель децибел с подсветкой ЖК-дисплея/максимальным удержанием/регулировкой чувс...

Если Вы считаете, что данное объявление нарушает правила нашего портала, то воспользуйтесь ссылкой "Пожаловаться"